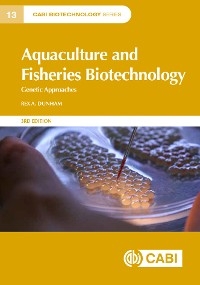
Aquaculture and Fisheries Biotechnology - Rex Dunham

Aquaculture and Fisheries Biotechnology (eBook)
648 Seiten
CABI (Verlag)
978-1-78924-346-8 (ISBN)
The genetic improvement of fish for aquaculture and related fisheries has seen huge advances over recent years. Building upon the previous two editions of Aquaculture and Fisheries Biotechnology: Genetic Approaches, this 3rd edition offers a presentation of traditional selective breeding, modern genetic biotechnology, genomics, gene transfer and gene editing, and the latest developments in genetic biotechnology such as epigenetics, xenogenesis and genome-wide association study coupled with commercial application, the impact of government regulation and expectations for the future. It provides a firm grounding in relevant aspects of classical genetics, before focusing on particular aspects such as sex reversal and breeding as applied in aquaculture and fisheries. It also explores how more recent molecular genetics, genomics and biotechnology techniques can be used and combined in improvement programmes for fish and aquaculture species. A glossary explains the latest terminology used in biotechnology and genetics.
This book will be useful for research scientists and students in marine biotechnology, aquaculture biotechnology, and fish genetics and breeding.
| Erscheint lt. Verlag | 28.2.2023 |
|---|---|
| Reihe/Serie | CABI Biotechnology Series | CABI Biotechnology Series |
| Verlagsort | Oxford |
| Sprache | englisch |
| Themenwelt | Naturwissenschaften ► Biologie ► Genetik / Molekularbiologie |
| Naturwissenschaften ► Biologie ► Limnologie / Meeresbiologie | |
| Technik | |
| Wirtschaft | |
| Weitere Fachgebiete ► Land- / Forstwirtschaft / Fischerei | |
| Schlagworte | Aquaculture • aquatic animals • Aquatic Organisms • aquatic species • Biotechnology • correlated responses • crossbreeding • DNA cloning • DNA hybridization • domestication • environmental effects • Environmental impact • environmental protection • fisheries • Food Safety • gene expression • Gene Mapping • genetically engineered animals • Genetically Engineered Organisms • genetically modified animals • Genetically Modified Organisms • genetic drift • gene transfer • genomics • genotype environment interaction • Genotypes • GEOS • GMOs • growth hormone • Hatcheries • Inbreeding • insulin-like growth factor • Insulin-like growth factor 1 • polyploids • Polyploidy • Population Genetics • Qualitative Analysis • Quantitative Analysis • Quantitative genetics • quantitative trait loci • quantitative traits • Regulations • risk, selection programme • Rules • selection programme • somatomedin C • Somatotropin • strains • Transgenic animals • Transgenic Organisms • wildlife conservation |
| ISBN-10 | 1-78924-346-7 / 1789243467 |
| ISBN-13 | 978-1-78924-346-8 / 9781789243468 |
| Informationen gemäß Produktsicherheitsverordnung (GPSR) | |
| Haben Sie eine Frage zum Produkt? |
Kopierschutz: Adobe-DRM
Adobe-DRM ist ein Kopierschutz, der das eBook vor Mißbrauch schützen soll. Dabei wird das eBook bereits beim Download auf Ihre persönliche Adobe-ID autorisiert. Lesen können Sie das eBook dann nur auf den Geräten, welche ebenfalls auf Ihre Adobe-ID registriert sind.
Details zum Adobe-DRM
Dateiformat: EPUB (Electronic Publication)
EPUB ist ein offener Standard für eBooks und eignet sich besonders zur Darstellung von Belletristik und Sachbüchern. Der Fließtext wird dynamisch an die Display- und Schriftgröße angepasst. Auch für mobile Lesegeräte ist EPUB daher gut geeignet.
Systemvoraussetzungen:
PC/Mac: Mit einem PC oder Mac können Sie dieses eBook lesen. Sie benötigen eine
eReader: Dieses eBook kann mit (fast) allen eBook-Readern gelesen werden. Mit dem amazon-Kindle ist es aber nicht kompatibel.
Smartphone/Tablet: Egal ob Apple oder Android, dieses eBook können Sie lesen. Sie benötigen eine
Geräteliste und zusätzliche Hinweise
Buying eBooks from abroad
For tax law reasons we can sell eBooks just within Germany and Switzerland. Regrettably we cannot fulfill eBook-orders from other countries.
aus dem Bereich